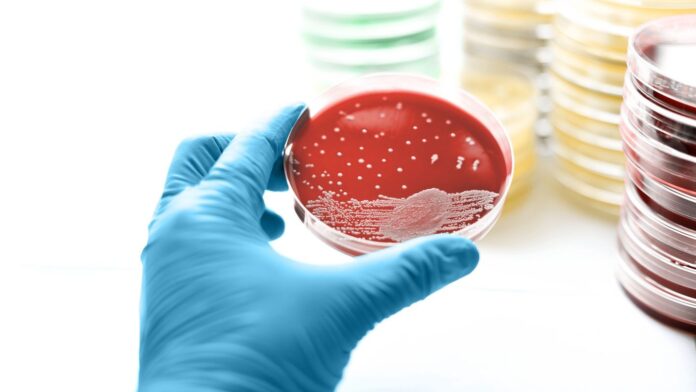
b42a213e-7c40-4d3f-a40e-474effc56cd3

Pseudomonas aeruginosa — поширена бактерія, яка може викликати широкий спектр інфекцій, від легкого подразнення шкіри до станів, що загрожують життю. Часто нешкідливо присутній на шкірі або у воді, він стає небезпечним, якщо потрапляє в організм через рани, медичні пристрої або забруднене середовище. Розуміння ризиків, симптомів і профілактичних заходів має вирішальне значення для захисту вашого здоров’я.
Що таке Pseudomonas aeruginosa?
Pseudomonas aeruginosa належить до групи бактерій, відомих своєю здатністю виживати в різноманітних умовах, включаючи ґрунт, воду та навіть лікарняне середовище. Центри з контролю та профілактики захворювань (CDC) ідентифікують його як найпоширеніший хвороботворний штам у роду Pseudomonas. Інфекції особливо серйозні для людей з ослабленою імунною системою або тих, хто проходить медичні процедури.
Як відбувається зараження?
Бактерія поширюється кількома шляхами:
- Заклади охорони здоров’я: Погана гігієна серед медичних працівників або заражене обладнання є основним джерелом інфекції.
- Вплив води: погано доглянуті гідромасажні ванни, басейни та навіть розчини для контактних лінз можуть містити P. aeruginosa, що призводить до інфекцій.
- **Рани: ** відкриті рани, опіки або місця хірургічного втручання забезпечують проникнення бактерій, особливо в лікарні.
- Медичні пристрої: Апарати штучної вентиляції легенів, катетери та інші інвазивні пристрої можуть бути забруднені, що призведе до інфекцій кровотоку чи сечовивідних шляхів.
Ризик підвищується для пацієнтів, які вже перебувають у лікарні, особливо тих, у кого ослаблений імунітет через основні захворювання або тривале лікування.
Симптоми та діагностика
Симптоми відрізняються в залежності від типу інфекції:
- Пневмонія: Кашель, утруднене дихання.
- Інфекції сечовивідних шляхів: Біль, часте сечовипускання.
- Ранові інфекції: Виділення рідини, запалення.
- Вушні інфекції: Біль, втрата слуху.
- Інфекції кровотоку: Лихоманка, озноб, що потенційно може призвести до шоку та відмови органів.
Діагностика включає фізичне обстеження та лабораторні дослідження для пошуку бактерій у крові чи рідинах організму. Лікарі часто проводять тестування на чутливість до антибіотиків, щоб визначити найбільш ефективне лікування.
Стратегії профілактики
Запобігання інфекції P. aeruginosa залежить від суворих гігієнічних заходів:
- Миття рук: необхідно часто мити руки з милом і водою або використовувати дезінфікуючий засіб для рук.
- Догляд за ранами: Тримайте рани чистими, накривайте їх і спостерігайте за ознаками інфекції.
- Уникайте спільного використання: Не діліться особистими речами, такими як бритви чи рушники.
- Застосування антибіотиків: Використовуйте антибіотики лише за призначенням і пройдіть повний курс лікування.
- Гігієна в охороні здоров’я: нагадайте медичним працівникам про дотримання правил гігієни рук перед спілкуванням з пацієнтами.
- Безпечне плавання: переконайтеся, що гідромасажні ванни та басейни належним чином хлоровані та доглядають.
Прогноз і ускладнення
Прогноз інфекції P. aeruginosa залежить від тяжкості, загального стану здоров’я та отриманого лікування. Рівень смертності коливається від 18% до 61%, при цьому найбільший ризик становлять інфекції крові та легенів. Неліковані ранові інфекції можуть призвести до інфекцій кісток, тоді як інфекції кровотоку можуть спричинити дихальну недостатність, шок і смерть.
Вразливі групи населення
Певні групи піддаються підвищеному ризику:
- Госпіталізовані пацієнти: ті, хто має рани, підключені до апаратів штучної вентиляції легень або використовують катетери.
- Пацієнти з муковісцидозом: Приблизно 25% людей з муковісцидозом мають хронічні легеневі інфекції P. aeruginosa.
- Люди з ослабленим імунітетом: люди з ВІЛ, раком, реципієнти трансплантації або приймають імунодепресанти.
Висновок
Pseudomonas aeruginosa є універсальним збудником, який може викликати серйозні інфекції в різних умовах. Дотримання суворої гігієни, безпечний догляд за ранами та належна медична санітарія є життєво важливими кроками для зниження ризику. Раннє виявлення та відповідне лікування антибіотиками покращують результати, але профілактика залишається найефективнішою стратегією.
Здатність бактерій пристосовуватися та розвивати стійкість до антибіотиків підкреслює необхідність продовження досліджень і ретельних заходів інфекційного контролю.